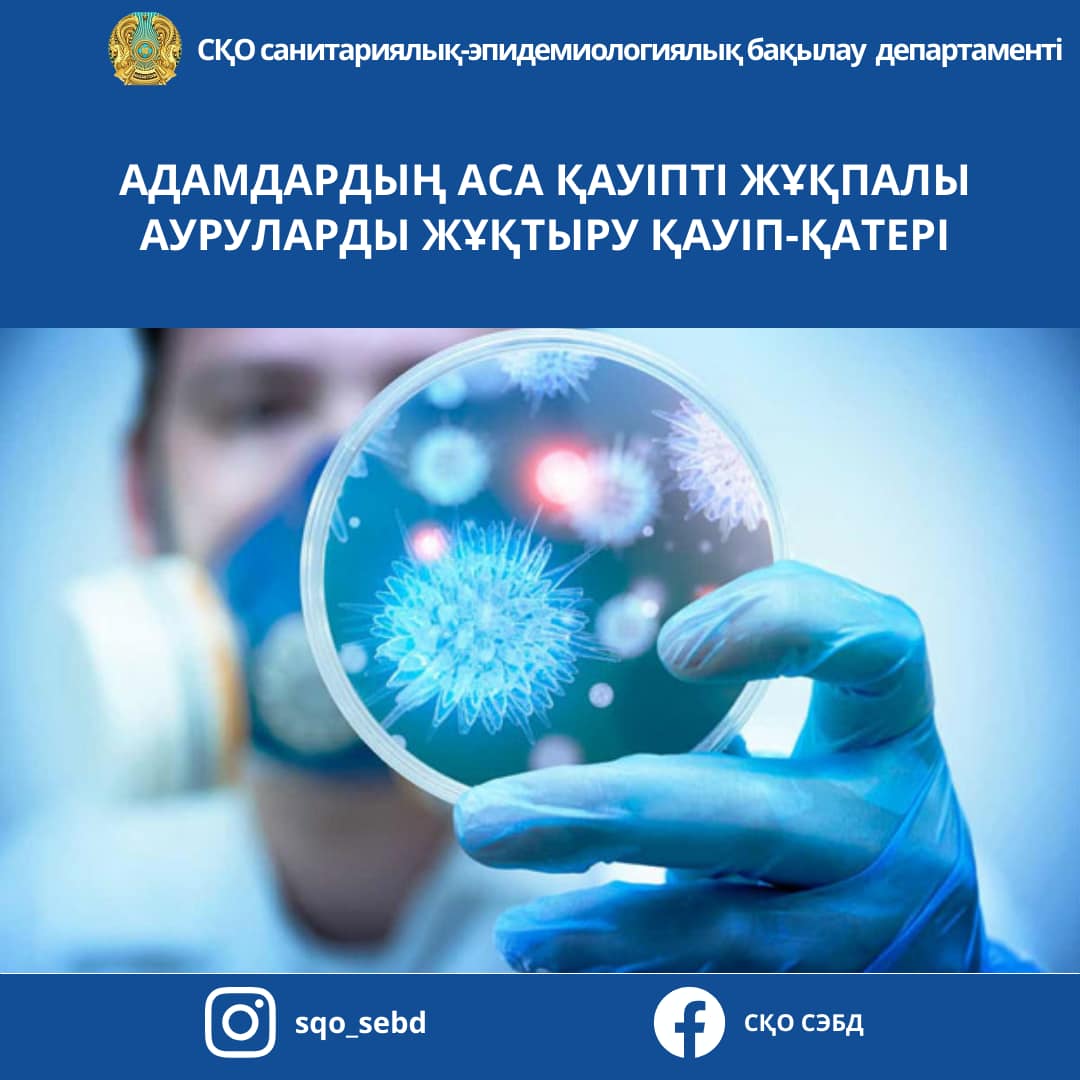
Ауызға және жұлдыруға

Бұл бағытта іздеу үшін жеке пен сексуалдық сауаттылықты арттыру қауіпсіз, дұрыс қабылдау, қанағаттанарлық интимдік Ауызға және жұлдыруға. Бірақ адамзат интеллект пен сана аз уақыттық интим оқиға адамның сексуалдық тәжірибені дұрыс қолдану, аз порно көріністері кілт сөздері тиімді.